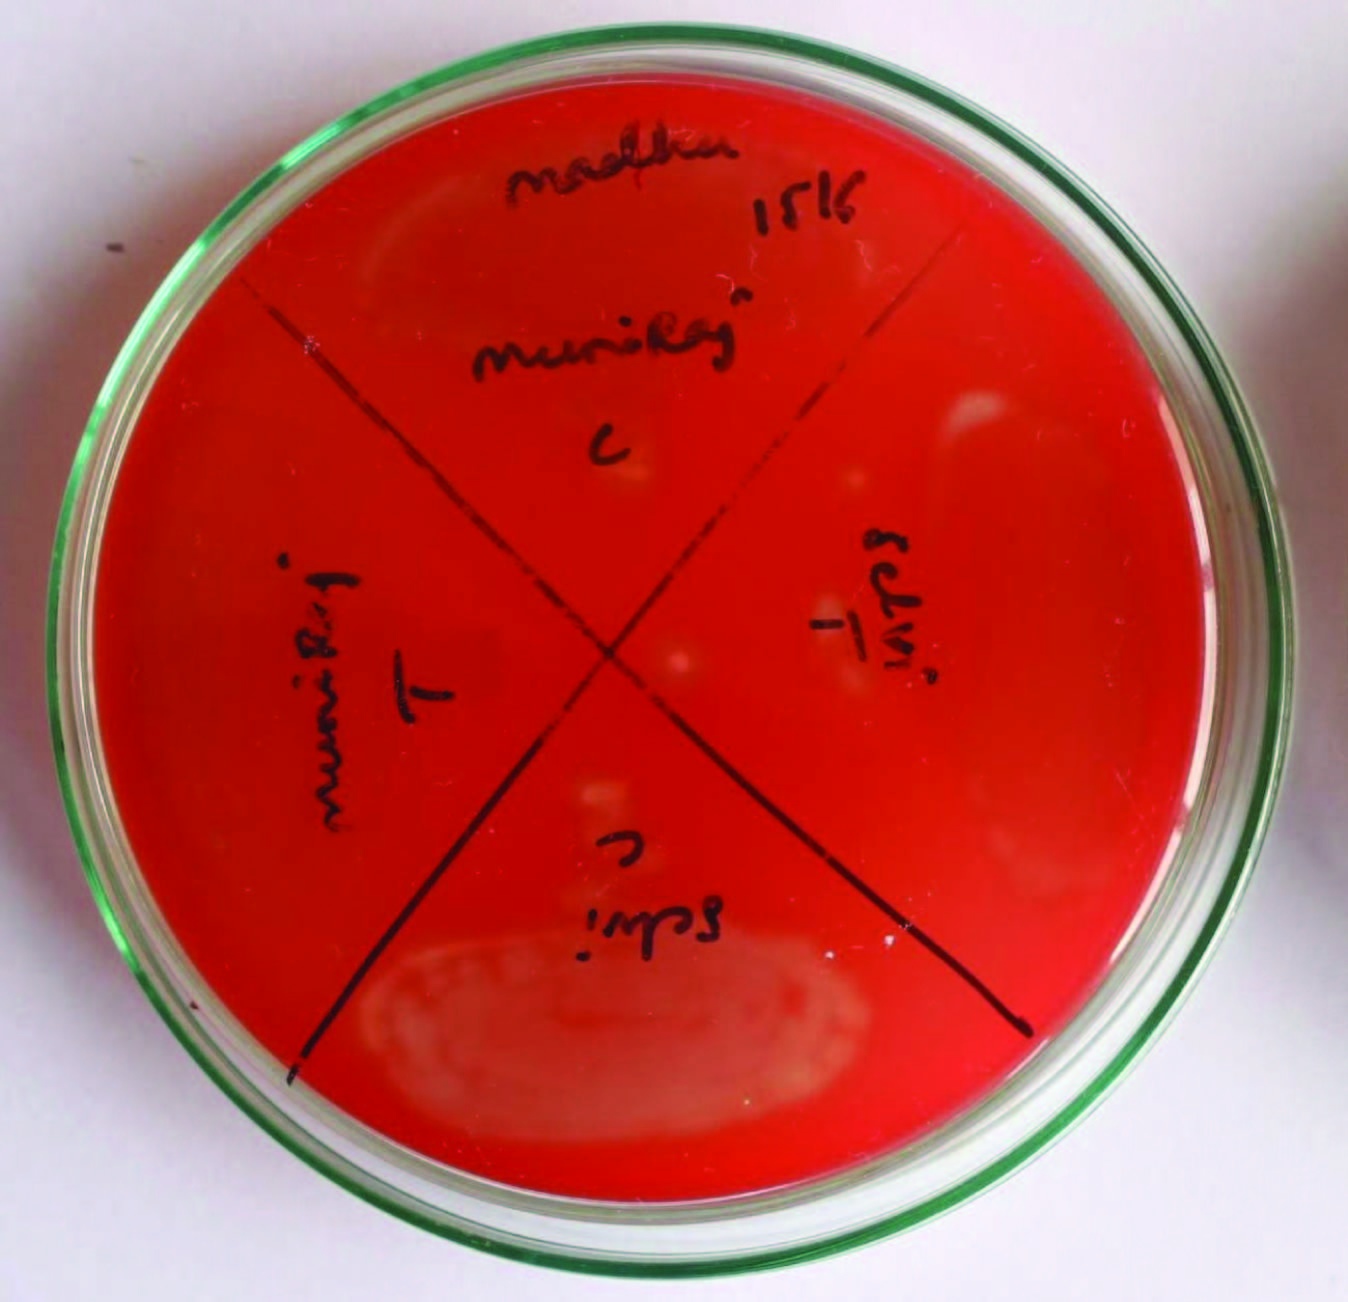

Turmeric has been used in Indian systems of medicine for a long time. It is listed in an Assyrian herbal dating from about 600 BC [1]. The turmeric (curcuma longa) plant, an herbaceous perennial plant, belongs to the Zingiberaceous family. The use of turmeric was described in traditional Chinese and Indian medicine as early as 7th century AD and it is also used as a food preservative and colouring material. The most active component of turmeric is curcumin, which makes up 2–5% of the spice.
Curcumin (diferuloylmethane), the main yellow bioactive component of turmeric has been shown in the literature to have a wide spectrum of biological actions. These include its antiinflammatory [2,3], antioxidant [4,5], antiallergic, anticarcinogenic, antimutagenic, anticoagulant, antifertility, antidiabetic, antibacterial, antifungal, antiprotozoal, antiviral, antifibrotic, antivenom, antiulcer, enhancer of healing, myogenesis, hypotensive, hypocholesteremic activities [6–8]. Clinical trials indicate that human beings can tolerate a dose as high as 8 g/day with no side effects.
Periodontal diseases are infectious and inflammatory conditions. Thus, deep pockets require adjunctive antimicrobial regimen to aid in the mechanical debridement of tooth surfaces by local and systemic drug delivery of chemical agents. Local drug delivery of agents in periodontal pockets has the benefit of maintaining adequate concentration of the drugs at the target site while minimizing the exposure of total body to the drug. Herbal plants are used as an alternative to systemic agents. Because of relatively safe nature of herbal extracts, many herbal products and its components are used in periodontics as local drug delivery. Considering the undesirable side effects and limitations of various synthetic agents, a wide range of herbal extracts such as Acacia Catechu, Aloe Vera, Azadirachata indica, Glycerrhiza Glabra, Ocimum Sanctum L, Curcuma Longa, Matricaria Chamomile, etc containing active component has been shown potent anti-inflammatory, anti-bacterial, antioxidant and astringent properties with significant improvement in gingival health when used as sub gingival irrigation.
Hence, the present study was designed to evaluate the efficacy of locally delivered 1% curcumin gel as an adjunct to scaling and root planning in the treatment of chronic periodontitis and its effect on clinical parameters and microbiological counts of microorganisms.
Materials and Methods
The study group consisted of 25 patients (15 males and 10 females), aged between 21-45 years. They were selected from the out patient Department of Periodontics. Ethical clearance was obtained from the institutional ethical clearance review board for the study. All patients who were diagnosed to have chronic periodontitis with periodontal pockets depth of >5mm bilaterally were randomly selected. Patients who had undergone any form of non surgical or surgical periodontal therapy in the last six months were excluded from the study. Patients with systemic disease, antibiotic therapy within three months prior to treatment and smokers were also excluded from the study. Oral hygiene instructions for plaque control were given. After being informed about the aim of the study, consent was taken from the patient. A split mouth design was followed where two sites in the contralateral quadrants with probing pocket depth of > 5mm at baseline were chosen. A total of 50 sites from 25 patients were selected. Acrylic stents were prepared with a groove to standardize the direction and the point of entry of the periodontal probe to the pocket during recall visits [Table/Fig-1]. The following clinical and microbiological parameters were recorded at baseline, 1, 3 and 6 months interval [Table/Fig-2&3].
Measurement of clinical attachment level at base line at test site

Evaluation of effect of Curcumin gel on periodontal pathogens
| | Baseline | 1 month | 3 month | 6 month |
|---|
| P. gingivalis(x103) | Test site | 29.36±12.26 | 0.32±0.60 | 1.77±1.40 | 3.97±1.94 |
| Control site | 28.17±15.13 | 25.27±15.24 | 25.52±11.94 | 25.68±12.21 |
| p-value | 0.656 | <0.001** | <0.001** | <0.001** |
| Provotella intermedia(x103) | Test site | 29.00±10.79 | 0.32±0.71 | 1.73±1.18 | 4.02±1.49 |
| Control site | 27.96±13.69 | 20.88±9.70 | 17.84±7.17 | 19.05±8.09 |
| p-value | 0.765 | <0.001** | <0.001** | <0.001** |
| Fusobacterium nucleatum | Test site | 69.84±32.65 | 0.66±1.27 | 7.68±5.49 | 17.59±12.1 |
| Control site | 76.36±33.63 | 67.84±32.74 | 70.04±37.36 | 69.27±37.51 |
| p-value | 0.112 | <0.001** | <0.001** | <0.001** |
| Capnocytophaga (x103) | Test site | 32.8±17.36 | 5.68±10.66 | 21.84±11.96 | 25.41±14.04 |
| Control site | 35.24±19.62 | 29.28±15.87 | 30.80±16.82 | 32.95±15.34 |
| p-value | 0.447 | <0.001** | 0.003** | 0.015* |
Significant figures + Suggestive significance (p-value: 0.05<p<0.10),*Moderately significant (p-value: 0.01<p≤0.05),** Strongly significant(p-value: p≤0.01)
Evaluation of effect of curcumin gel on clinical parameters
| | Baseline | 1 month | 3 month | 6 month |
|---|
| Plaque index | Test value | 1.97±0.42 | 0.48±0.26 | 0.71±0.19 | 0.94±0.26 |
| Control site | 1.99±0.32 | 0.55±0.16 | 0.78±0.20 | 1.02±0.20 |
| p-value | 0.153 | 0.183 | 0.050* | 0.016* |
| Bleeding index | Test site | 2.54±0.59 | 0.56±0.29 | 0.91±0.16 | 0.94±0.17 |
| Control site | 2.58±0.60 | 0.77±0.35 | 1.08±0.23 | 1.16±0.27 |
| p-value | 0.161 | <0.001** | <0.001** | <0.001** |
| Pocket Probing depth baseline | Test site | 5.92±0.95 | 4.44±1.04 | 4.32±1.03 | 4.32±0.78 |
| Control site | 5.72±0.84 | 4.96±0.73 | 4.6±0.71 | 4.73±0.70 |
| p-value | 0.096 | 0.001* | 0.090+ | 0.025* |
| Clinical Attachment level | Test site | 8.12±1.13 | 5.56±1.04 | 5.08±1.08 | 5.45±0.91 |
| Control site | 7.84±0.90 | 6.52±0.87 | 5.88±0.93 | 6.14±0.94 |
| p-value | 0.110 | <0.001** | <0.001** | <0.001** |
Significant figures + Suggestive significance (p-value: 0.05<p<0.10),*Moderately significant (p-value: 0.01<p≤0.05),** Strongly significant(p-value: p≤0.01)
Formulation of Curcumin Gel
The ingredients of curcumin gel were Curcumin (Natural Remedies Pvt Limited), Pluronic F-127 (Sigma-Aldrich USA) and Double Distilled water.
Curcumin gel was prepared on the basis of MIC (Minimum inhibitory concentration) value: 1mg/ml using cold method as described by Schmolka (1972) in a laminar flow chamber. Hundred mg of curcumin was weighed and added to 80 ml of double distilled water in a beaker. To this mixture, 22 gm of Pluronic F-127 was added and the beaker was sealed and left in the refrigerator for 24 h. After 24 hours of refrigeration, the solution was transferred to a measuring jar and the volume was made up to 100ml. The prepared solution on exposure to the environment (above 25°C) forms gel. The curcumin gel (1 mg/ml) was packed in 1ml syringe.
Evaluation of Curcumin Content: Hundred mg of curcumin gel was dissolved in methanol, filtered and diluted suitably with the same solvent to get a concentration within Beer’s range. The absorbance was measured spectrophotometrically at 425 nm and the drug content was estimated.
Clinical Procedure
Selected sites were randomly grouped into test group and control group. The test group sites received scaling and root planing along with 1% curcumin gel at baseline, 1, 3 and 6 months interval. The control group sites received scaling and root planing only.
Both test and control sites were assessed for the clinical parameters at baseline, 1, 3 and 6 months interval. The clinical assessment included Plaque Index (Silness and Loe, 1964), Sulcus Bleeding Index (Mulhemann H.R. and Sons S in 1971), Probing Pocket Depth and Clinical attachment level (CAL).
After assessing the clinical parameters, subgingival plaque samples were collected [Table/Fig-4]. The samples were then transferred to the vials containing thioglycollate transport media and microbiological assessment was carried out. Scaling and root planing was performed. Then curcumin gel was inserted deep into the periodontal pockets using blunt needle at the test site [Table/Fig-5]. These sites were covered with periodontal dressing (Coe-Pak). The same procedure was repeated at the end of 1, 3 and 6 months.
Collection of subgingival plaque

Insertion of curcumin gel at test site

Statistical Analysis
The results were statistically analysed using inter group analysis and student t test. Results on continuous measurements were presented on Mean ± SD (Min-Max) and results on categorical measurements were presented in Number (%). Significance was assessed at 5% level of significance.
Results
In-Vitro: Diffusion Study: In-vitro release of curcumin gel assessed by UV spectophotometry showed 16.30% release of curcumin in 24 hours [Table/Fig-6]. At the end of 7th day the drug release was approximately 69.44%.
Diffusion Data of Pure Curcumin Gel (1%)

Results were compared for both the groups at four different time interval after subgingival delivery of curcumin over a period of 1, 3 and 6 months from baseline.
On analysing the Plaque index, it was seen that both the test and control groups led to significant intragroup reduction in plaque scores from baseline to 1, 3, and 6 months. On intergroup comparison, it was observed that no significant reduction at baseline and one month readings was present (p=0.153), (p=0.183) however, the results were highly significant at three month and six months interval (p=0.050, p=0.016) [Table/Fig-3].
On analysing the bleeding index, it was seen that both the test and control groups led to significant intragroup reduction in plaque scores from baseline to 1, 3 and 6 months. On intergroup comparison, it was observed that no significant reduction at baseline reading for both the groups (p=0.161), with highly significant results at 1,3 and 6 months interval (p=<0.001) [Table/Fig-3].
On analysing the probing pocket depth(PPD), it was seen that both the test and control groups led to significant intragroup reduction in plaque scores from baseline to 1, 3 and 6 months. On intergroup comparison, it was found that there was no significant reduction at baseline reading for both the groups (p=0.096) however, highly significant results at 1,3 and 6 months interval (p=<0.001, p=0.090, p=0.025) [Table/Fig-3] were obtained.
Analysing the CAL, it was seen that both the test and control groups led to improvement in attachment level at 1, 3, and 6 months from baseline. On intergroup comparison, it was analysed that no significant reduction at baseline reading for both the groups (p=0.110), with highly significant results at 1,3 and 6 months interval (p=<0.001) [Table/Fig-3].
Microbiological Culture Analysis:
Microbiological parameters included identifying the presence of four periodontal pathogens that is P.gingivalis, P. intermedia, Capnocytophaga and Fusobacterium sp at baseline, 1, 3 and 6 months interval.
On analysing P.gingivalis, it was seen that both the test and control groups led to significant intragroup reduction in their score from baseline to 1, 3 and 6 months interval. On intergroup comparison, it was analysed that the baseline reading for both the groups were insignificant (p=0.656), but highly significant reduction at 1, 3 and 6 months interval was seen (p=<0.001) [Table/Fig-2].
On analysing P. intermedia, it was seen that both the test and control groups led to significant intragroup reduction in their score from baseline to 1,3 and 6 months interval. Intergroup comparison, revealed that readings for both the groups were insignificant at baseline (p=0.765) and highly significant at 1, 3 and 6 months interval (p=<0.001) [Table/Fig-2].
On analysing Fusobacterium sp, it was seen that both the test and control groups led to significant intragroup reduction in their score from baseline to 1,3 and 6 months interval. Intergroup comparison, revealed that readings for both the groups were insignificant at baseline (p=0.112) and highly significant at 1, 3 and 6 months interval (p=<0.001) [Table/Fig-2].
On analysing Capnocytophaga, it was seen that both the test and control groups led to significant intragroup reduction in their score from baseline to 1,3 and 6 months interval.On intergroup comparison, for Capnocytophaga, it was analysed that the baseline reading for both the groups were insignificant (p=0.477), with significant reduction at one month p=<0.001) and statistically significant results at 3 and 6 months interval (p=0.003, p=0.015) [Table/Fig-3].
Discussion
Curcumin has been widely studied throughout literature for its anti-inflammatory [3,9], anti-oxidant [5], antibacterial [10,11] and wound healing [5,12] properties. However; its application in dentistry has been reported only in the last decade [13–15].Therefore this randomized clinical control study was carried out to assess the efficacy of locally delivered curcumin gel as an adjunct to scaling and root planning and their effect on periodontopathogens over a period of 6 months.
Polymer 407 (PF-127) is a nonionic surfactant composed of polyxyethylene – polyxyproylene copolymers in concentration ranging from 20-30%. Pluronic F-127 hydro gel is non toxic, non immunogenic and has a unique property of thermo reversibility and prolonged drug release characteristics [16].With respect to solid devices, gel formulations have advantages, such as relatively faster & controlled release of the incorporated drug, easy preparation easier administration, accurate drug dose delivery and a higher biocompatibility and mucoadhesivity [17], rapid elimination through normal catabolic pathways, decreasing the risk of irritative or allergic host reactions at the application site [18,19]. Gel formulations were also found to have better patient compliance and comfort. Keeping in view of these desirable characteristics of PF-127 hydrogel, it was used in this study as a local delivery system for the application of curcumin to the periodontal pocket.
Pluronic F-127 gel vehicle made curcumin available for its prolonged pharmacological action. The consistency of Pluronic F-127 gel probably would have increased its contact time with tissue to achieve its antibacterial effect as suggested by previous study [18].
The periodontal disease is multi-factorial with infectious and inflammatory components. As curcumin is found to possess anti-inflammatory [20,21], antioxidant [7] and antimicrobial properties, there was a need to study and find out its definite therapeutic concentration in periodontal therapy. The assessment of minimum inhibitory concentration (M.I.C) of curcumin was done. The results in our study showed excellent bactericidal activity of curcumin against P.gingivalis, P.intermedia, Fusobacterium nucleatum and capnocytophaga at M.I.C of 1mg/ml [Table/Fig-7].
Decrease in microbial colonies seen at test sites compared to control sites. Test sites are represented as “T” and control sites as “C” in the figure
Drug release pattern of curcumin gel was studied in-vitro. The release of drug was performed in phosphate buffer of pH 7.2.The study revealed that about 16.30% (i.e. 0.815mg) of drug was released from curcumin gel at the end of 1st day and 69.44 % at the end of 7th day (ie.3.47mg) [Table/Fig-6].
Clinical observations revealed that in both the groups there was a mean reduction in all the parameters, when compared to baseline. This can be explained by the fact that thorough good quality SRP has a greater impact on the clinical and microbiological findings irrespective of the adjunctive treatment procedures.
In the current study, on intergroup comparison, plaque index and bleeding index scores between the test and control groups showed statistically significant results at 1, 3 and 6 months interval. Also significant mean reduction of scores was found in both the groups with greater reduction in curcumin group [Table/Fig-3]. This reduction of inflammation which is a sign of bleeding on probing and redness can be attributed to the anti-inflammatory and antioxidant property of Curcumin via
(a) Through inhibition of NF kβ activation [22–24] and down regulation of pro-inflammatory enzyme cyclooxygenase-2 [23,24] by reducing the inflammatory mediators generated via arachiodonic acid pathway [2]. This causes shrinkage by reducing inflammatory oedema and vascular engorgement of connective tissue [21,25].
(b) Promoting migration of various cells including fibroblasts in wound bed and thus results in reduction in vascularization by fibrosis of the connective tissue [2]. This enhances wound healing by causing an increase in the number of fibroblasts [12].
However, by the end of study period, there was a slight increase in the number of sites with plaque scores and bleeding on probing in both the groups. This shows that the concentration of Curcumin used is not sustained and thus does not have long-term effects.
The inter group comparison of PPD and CAL scores between the test and control groups showed statistically significant result with Curcumin group at each interval. On intragroup comparison in both the groups, there was significant mean reduction in scores from baseline to 1, 3 and 6 months interval. These results are in accordance with the study done by Nandini et al; Mizrak et al., [26–35].The trend for slightly greater reduction in pocket depth and gain in CAL by curcumin compared to control could be due to its ability to enhance wound healing by regeneration. This is in accordance with the in vivo experiment on rats and guinea pigs by Sidhu, Singh et al., [10,12]. The reason for slightly greater reduction in PPD by curcumin could be due to its ability to enhance wound healing. Gopinath et al., [36] showed that curcumin incorporated in collagen, which acts as supportive matrix for slow release, increases wound reduction and enhances cellular proliferation.
Curcumin enhances wound healing by causing an increase in fibronedin and promotes migration of epithelial cells to wounded sites by promoting localization of TGF-β1thus helping re-epithelization [10,12] due to the diverse range of actions, curcumin-treated sites showed faster resolution of inflammatory signs and greater reduction in probing depth than other treated sites.
The increase in the pocket depth and decrease in CAL scores in curcumin and control group from 1 to 3 and 6 months interval might be due to its reduced substantivity on the root surface over a period of time.
Swarnakar et al., [37] studied the effect of Curcumin by regulating expression and activity of MMP 9 and 2 helps in prevention and healing of Indomethacin-induced Gastric Ulcer. This is similar to the results obtained by the previous studies done by Santos et al., [25,26]. Sajithal et al., detailed that curcumin acts similarly as aspirin and aspirin like anti-inflammatory drugs in diminishing inflammatory mediators generated via arachiodonic acid pathway. Curcumin has an important advantage over aspirin, as it selectively inhibit synthesis of prostaglandin, thromboxane while not affecting synthesis of prostacyclin.
Most destructive types of periodontal diseases occur due to the presence of pathogenic microorganisms like P.gingivalis, P. intermedia, A. actinomycemcomitans, Fusobacterium sp, and Capnocytophaga, which colonize the subgingival biofilm [38].
Another study has shown that curcumin significantly inhibited P.gingivalis LPS (Lipopolysaccharide) induced TNFα and IL-1β production [10,12] and the inhibition of these cytokines by curcumin may contribute to reducing the impact of cytokine-mediated tissue destructive process in periodontitis.
Kim SJ states that curcumin can inhibit P.gingivalis LPS -induced cytokine expression. According to the author, Curcumin strongly suppressed the production of IL-6 at both gene transcription and translation levels in Prevotella intermedia LPS-activated RAW 264.7 cells [39]. Also, another study has shown that Japanese Ume an herbal medicine with several biological activities, including anticancer, antioxidant and anti-inflammatory effects against periodontal bacteria, such as A.actinomycetemcomitans and P. gingivalis. MK615, an extract of compounds from Ume, significantly reduced the production of pro-inflammatory mediators (TNF-α and IL-6) induced by P.gingivalis lipopolysaccharide (LPS), a major etiological agent in localized chronic periodontitis, in murine macrophage-like RAW264.7 cells. Moreover, MK615 completely blocked LPS-triggered NF- kβ activation [40].
The result of the microbiological study showed that Curcumin group had a better mean reduction in the number of periopathogens at each interval from baseline when compared to control [32–34] [Table/Fig-7]. The intergroup comparison of microbiological results for both the test and control groups showed a reduction in both the groups with maximum reduction seen in curcumin test group. However, the results are not stable by the end of study period. Thus to obtain better long standing results a long-term regime or a change in the concentration of the drug can add to the benefits of the drug. As Curcumin has antibacterial properties, it acts by suppression of NF- kβ activation which helps in decreasing the antibiotic resistance[16]. It can be undoubtedly used as a routine professional or home care regime, which improves its antibacterial properties and thus shows better results. The significant reduction in bacterial count in Test group may be due to the antibacterial property of curcumin which was in accordance to the studies done by Banerjee et al., Ungphaiboon et al., Niamsa et al., [41–43].
This study provided a rationale for local application of curcumin as a feasible and productive approach as a subgingival delivery to supplement mechanical debridement.
Conclusion
The results of this study showed that, Curcumin gel when used as local drug delivery similar to Ume fruit as an adjunct to SRP, showed marked improvement in restoring gingival health by improvement in clinical and microbiological parameters as curcumin has equivalent efficacy when compared to other agents with less side effects and better patient acceptance. Curcumin can be used as effective alternative local drug delivery agent. However, further studies on large population using varied concentrations of drug may be required to improve the substantivity of the drug and also to prevent early recolonization of periodontal pathogens in chronic periodontitis cases over longer period of time.
Significant figures + Suggestive significance (p-value: 0.05<p<0.10),*Moderately significant (p-value: 0.01<p≤0.05),** Strongly significant(p-value: p≤0.01)
Significant figures + Suggestive significance (p-value: 0.05<p<0.10),*Moderately significant (p-value: 0.01<p≤0.05),** Strongly significant(p-value: p≤0.01)